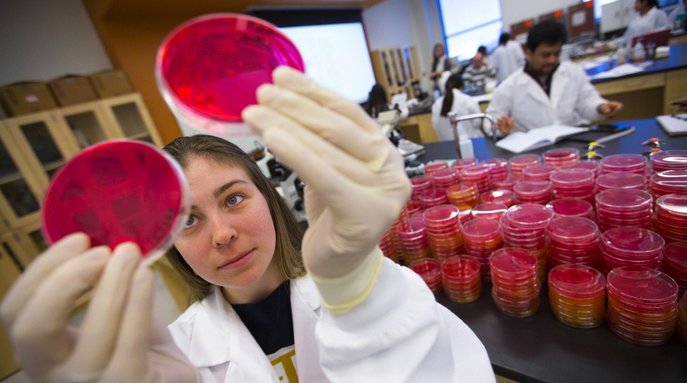
Women in Science workshops to focus on mentorship. bit.ly/2arEkX1 #UNL #LNK #IANRSciLit

Lia Marchi Werle
@werlelia
ID: 3403598591
05-08-2015 02:13:32
25 Tweet
52 Takipçi
53 Takip Edilen

These events are great examples of how Nebraska research directly impacts agricultural producers across the state, with the help of Nebraska Extension educators and specialists. #NUforNE


Thankful for the opportunity to be back in Nebraska presenting Soy Mgmt Field Days. Excellent program put together by Nebraska Extension Keith Glewen and team, supported by Nebraska Soybean Board









One of the most exciting accomplishments. #UNL thank you Tiffany Heng-Moss and Tom Hunt x.com/unlcroppingsys…






Amit Jhala @UNLCroppingSyst Nebraska CropWatch Great demo using smoke bombs to show off-target movement during inversion x.com/_HopeLong/stat…